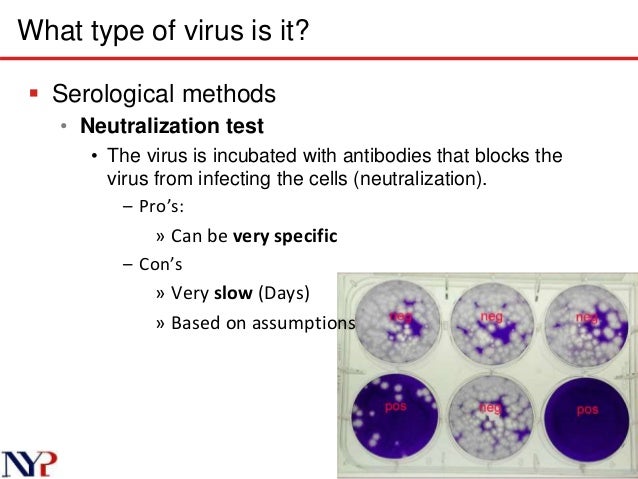

Are you ready to find 'neutralization test for virus'? You will find all the information on this section.
Table of contents
- Neutralization test for virus in 2021
- Virus neutralization test wikipedia
- Neutralization test microbiology
- Virus neutralization test procedure
- Serum virus neutralization assay
- Neutralization test used for
- Surrogate virus neutralization test
- Virus neutralization test protocol
Neutralization test for virus in 2021
Virus neutralization test wikipedia

Neutralization test microbiology

Virus neutralization test procedure

Serum virus neutralization assay
Neutralization test used for

Surrogate virus neutralization test

Virus neutralization test protocol

Which is the best neutralization test for RABV?
The current gold standard RABV neutralization assays, such as rapid fluorescent focus inhibition test (RFFIT) or FAVN, report antibody titers as international units/mL (IU/mL). The PVNA currently only reports antibody titers in reciprocal dilutions.
How are antibodies used in the neutralization test?
Inoculation of viruses in cell cultures, eggs, and animals results in the replication and growth of viruses. When virus-specific neutralizing antibodies are injected into these systems, replication and growth of viruses is inhibited. This forms the basis of virus neutralization test.
What does it mean to neutralize a virus?
Virus neutralization test Neutralization of viruses by their specific antibodies are called virus neutralization tests. Inoculation of viruses in cell cultures, eggs, and animals results in the replication and growth of viruses.
How is antiserum prepared for a neutralization test?
The antiserum is titrated in the neutralization test against its homologous virus. Serial twofold dilutions of serum is prepared and mixed with an equal volume containing 100TCID50 of virus. The virus and serum mixtures are incubated for 1 hour at 37oC.
Last Update: Oct 2021